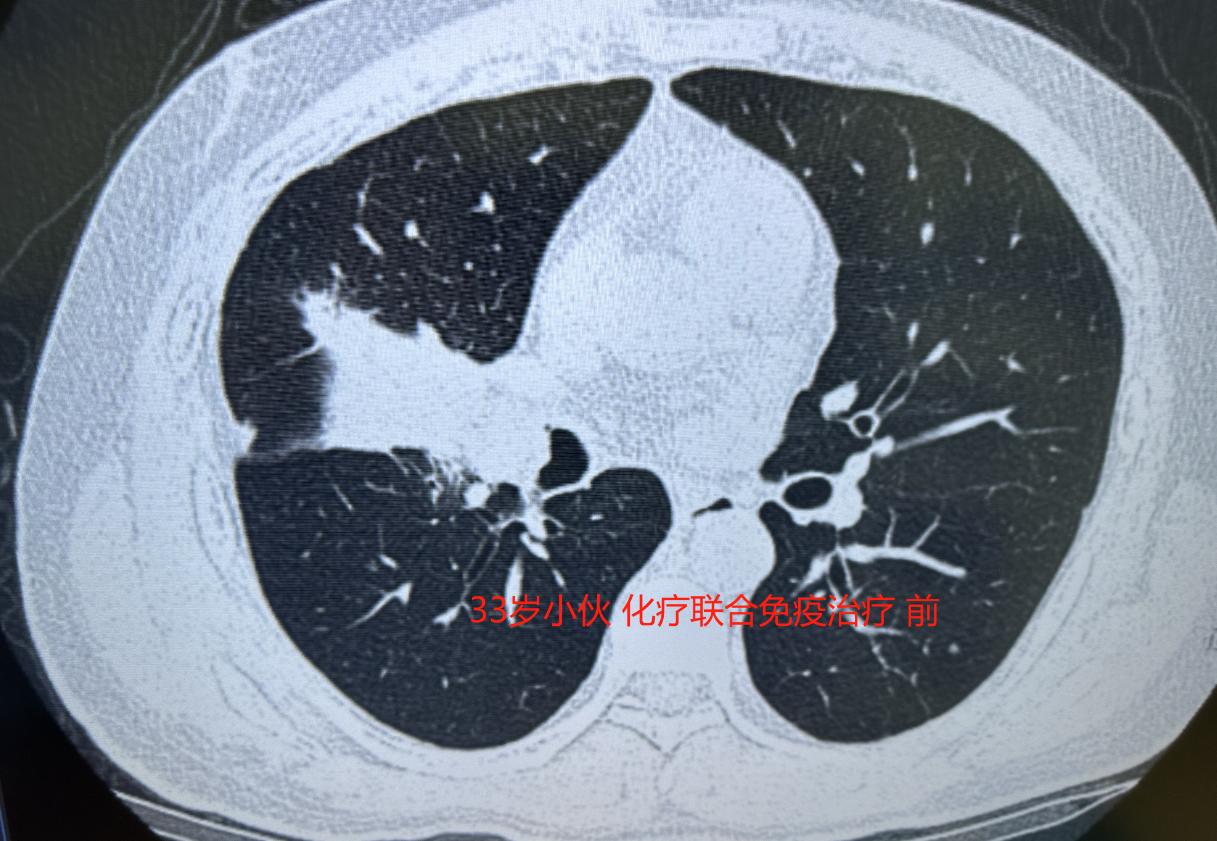

33岁的年轻人,因为咳嗽得厉害去检查,发现右肺中叶长了一个很大的肿瘤,进一步检查确诊肺癌,幸好还没有转移到其他地方,但整个右肺中叶几乎被肿瘤占满,周围的血管和气管也都受到了侵犯。 按照常规,像他这样没有基因突变的肺癌患者,目前效果比较好的方案是先做“化疗联合免疫治疗”,等肿瘤缩小后再手术,这样切除得更彻底。有效率本来有百分之七八十,算是比较高的。 但没想到,三次治疗下来,肿瘤一点都没缩小——这个方案对他竟然没起作用。 说实话,我心里挺沉重的......这么年轻,孩子还小,他比谁都渴望活下去。 作为医生,我也清楚,这不只是一个人的生命,更关系着一个家庭的未来。 既然药物治疗效果不好,我们团队商量后,决定直接手术。虽然风险大,但只有放手一搏,才可能有转机。手术采用微创胸腔镜,但因为肿瘤侵犯范围广,血管气管处理起来非常困难。 原本计划做袖状切除,但在手术中实际探查后,我们发现做“右肺中下叶联合切除”更稳妥、也更干净。于是术中果断调整了方案。 很庆幸,手术比预期还要顺利,肿瘤被完整切除了。 记得手术前,我和他认真聊过:手术有风险,我不能保证百分之百成功,但如果不去尝试,就一点机会都没有了。他听完,很勇敢地选择了信任我们。 这件事让我更深刻地感受到,面对棘手的病情,患者的勇气和医生的坚持,往往能一起推开那扇看似关着的门。 医学有时确实存在不确定性,但我们能做的,就是在不确定中尽力寻找确定——不放弃任何可能,才有机会等到转机。 如今回想起来,仍然为这个年轻人高兴。也想对大家说,无论遇到多难的情况,主动面对、积极行动,希望往往就在前方等着我们。[玫瑰][作揖]